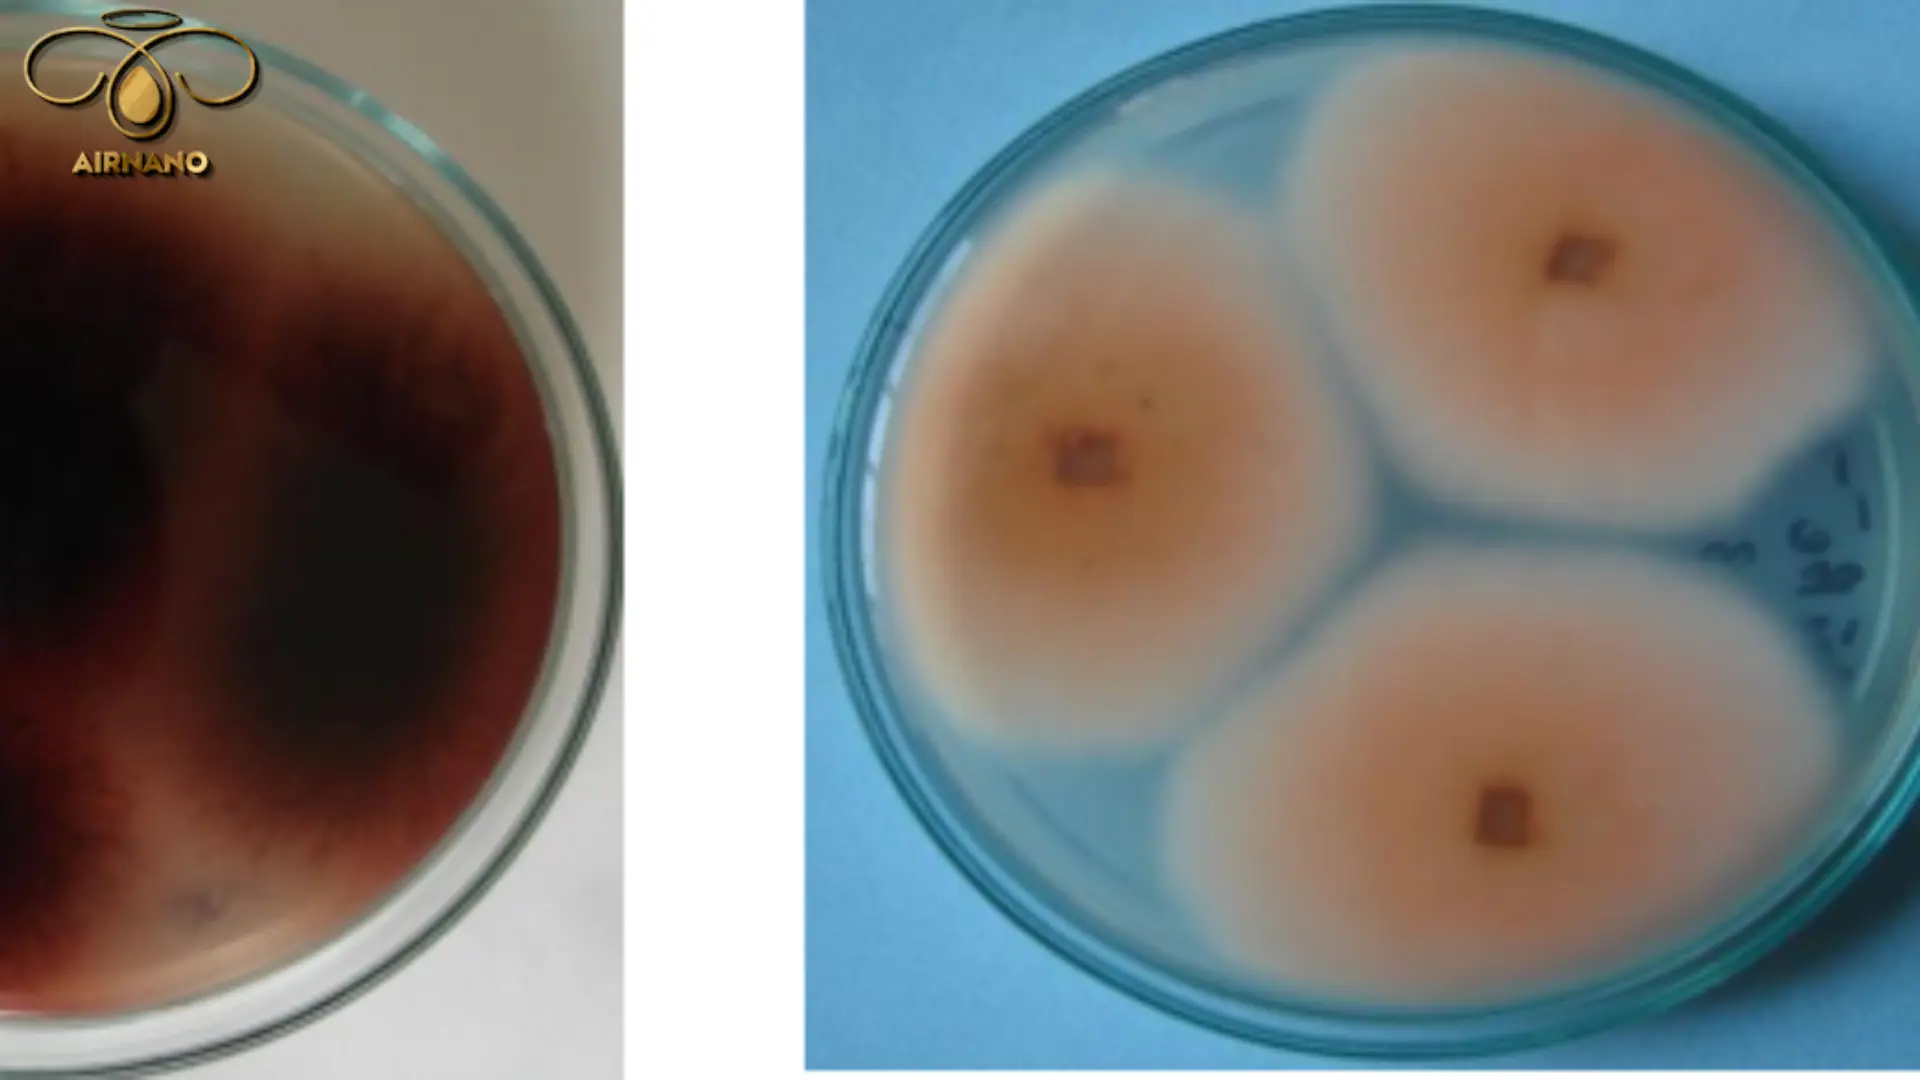
Nguyên nhân gây bệnh lúa von

Bệnh lúa von, hay còn gọi là “lúa đực”, “mạ đực” (tên tiếng Anh: Bakanae disease), là một mối đe dọa lớn đối với cây lúa, gây suy yếu cây trồng, giảm năng suất và làm suy giảm chất lượng hạt. Trong bài viết này, Airnano sẽ đưa bạn vào hành trình khám phá chi tiết về bệnh lúa von, từ nguồn gốc, dấu hiệu nhận biết, đến những giải pháp tối ưu để kiểm soát và ngăn chặn bệnh.
Tác Nhân Gây Bệnh
Bệnh lúa von xuất phát từ nấm Fusarium moniliforme, một loại nấm nguy hiểm phát triển mạnh trong điều kiện nhiệt độ từ 10–37°C, với “vùng thoải mái” lý tưởng là 24–32°C, kết hợp độ ẩm cao và ánh sáng yếu. Loại nấm này tạo ra bào tử có khả năng tồn tại dai dẳng trong đất, trên hạt giống hoặc cây trồng từ 4–6 tháng, sẵn sàng chờ cơ hội tấn công.
Bệnh lây lan qua gió, hạt giống nhiễm bệnh hoặc từ các mầm bệnh còn sót lại trên đồng ruộng. Nấm thường “ưu ái” tấn công phần gốc, rễ cây lúa, nhưng hiếm khi gây hại cho lá, bẹ hay thân trên. Không chỉ “đeo bám” cây lúa, nấm Fusarium moniliforme còn “ghé thăm” các cây họ hòa thảo khác và một số cây trồng phụ như cà chua, đậu, chuối, khiến việc kiểm soát càng thêm thách thức.
Dấu Hiệu Nhận Biết
Bệnh lúa von thường “ẩn mình” trong hạt giống và bộc phát từ giai đoạn mạ non cho đến khi lúa trổ bông. Cây lúa nhiễm bệnh sẽ có những biểu hiện bất thường, dễ nhận biết:
-
Vươn cao bất thường: Mạ lúa có thể cao gấp 2–3 lần so với cây khỏe mạnh, nhưng thân mảnh mai, yếu ớt, dễ gãy.
-
Màu sắc kỳ lạ: Lá lúa chuyển từ xanh nhạt sang vàng, thậm chí đỏ như gạch cua, trước khi cây chết dần.
-
Chết nhanh: Cây nhiễm bệnh thường không chịu nổi và héo rũ chỉ trong thời gian ngắn.
-
Triệu chứng “lùn bất thường”: Trong một số trường hợp, do độc tố nấm tiết ra dưới thời tiết thay đổi, cây lúa có thể thấp lùn bất thường thay vì vươn cao.
Ở giai đoạn muộn, cây lúa nhiễm bệnh giảm số chồi hữu hiệu, lá cờ nhợt nhạt, yếu ớt, xuất hiện rễ khí sinh. Khi độ ẩm cao, đốt thân lúa có thể phủ một lớp phấn trắng hồng – dấu hiệu của bào tử nấm. Bệnh phát triển mạnh ở những ruộng lúa bón thừa đạm và nhiệt độ cao, tạo điều kiện lý tưởng cho nấm hoành hành.

Hậu quả của bệnh lúa von
Bệnh lúa von không chỉ làm cây mạ chết hàng loạt mà còn gây thối gốc, khiến cây lúa khó sống sót đến giai đoạn trổ bông. Những cây “may mắn” sống sót thường có thân vươn dài bất thường, rễ bất định mọc ở các lóng dưới. Khi trời ẩm, lớp phấn trắng hồng xuất hiện; còn khi khô ráo, những chấm xanh đen nhỏ li ti (quả thể nấm) lộ diện, báo hiệu sự hiện diện của nấm.
Hạt lúa từ cây nhiễm bệnh thường lép, lửng, dẫn đến năng suất giảm nghiêm trọng, có thể lên đến 50%. Đáng lo hơn, mầm bệnh vẫn “lưu trú” trong hạt giống và đất, tiếp tục lây lan qua các vụ mùa sau, tạo thành một vòng luẩn quẩn khó phá vỡ.
Giải Pháp Phòng Trừ Chống Lại Bệnh Lúa Von
Để kiểm soát bệnh lúa von, cần kết hợp các biện pháp canh tác thông minh, hóa học hiệu quả và sinh học thân thiện với môi trường. Dưới đây là những chiến lược cụ thể:
Biện Pháp Canh Tác
-
Chọn giống sạch, kháng bệnh: Ưu tiên giống lúa thuần, xác nhận từ các đơn vị uy tín. Tránh sử dụng hạt giống từ vụ trước nếu ruộng đã bị nhiễm bệnh. Tìm hiểu thêm về cách xử lý giống trước khi gieo sạ để đảm bảo “lá chắn” đầu tiên cho cây lúa.
-
Canh tác cẩn thận: Hạn chế làm tổn thương rễ, chồi lúa để tránh tạo “cửa ngõ” cho nấm xâm nhập. Gieo sạ với mật độ hợp lý và bón phân cân đối, tránh lạm dụng phân đạm.
-
Theo dõi đồng ruộng: Thường xuyên kiểm tra ruộng lúa, đặc biệt ở giai đoạn mạ và làm đòng. Nếu phát hiện cây bệnh, nhổ bỏ ngay và tiêu hủy xa ruộng để ngăn lây lan.
Biện Pháp Hóa Học
-
Xử lý giống: Ngâm ủ hạt giống với các sản phẩm chứa hoạt chất diệt nấm để tiêu diệt mầm bệnh ngay từ đầu.
-
Phun thuốc khi cần: Khi ruộng xuất hiện dấu hiệu bệnh, sử dụng thuốc bảo vệ thực vật chứa hoạt chất như Carbendazim để khống chế nấm. Lưu ý tuân thủ hướng dẫn từ nhà sản xuất để đảm bảo an toàn cho người và môi trường.
Biện Pháp Sinh Học
Sử dụng các chế phẩm sinh học chứa nấm đối kháng như Trichoderma (đặc biệt là Trichoderma asperellum và Trichoderma atroviride Karsten) để tiêu diệt mầm bệnh ngay trong giai đoạn ngâm ủ giống. Đây là giải pháp an toàn, thân thiện với môi trường, giúp bảo vệ cây lúa một cách bền vững.

Giải pháp phun thuốc trừ bệnh lúa von bằng máy bay xịt thuốc
Trong bối cảnh thiếu hụt lao động nông nghiệp, việc phun thuốc trừ bệnh bằng phương pháp thủ công trở nên khó khăn và kém hiệu quả. Giải pháp tiên tiến từ Airnano – máy bay phun thuốc không người lái đang thay đổi cách nông dân đối phó với bệnh lúa von.
Máy bay phun thuốc Airnano, như các dòng DJI Agras T50, T30, T20P, T40, mang lại hiệu quả vượt trội:
-
Tốc độ vượt bậc: Chỉ mất 10 phút để phun thuốc trên 1 hecta, nhanh gấp 20 lần lao động thủ công.
-
Tiết kiệm tối đa: Giảm 30% lượng thuốc, 90% nước, đảm bảo phun đều, không chồng lấn, không giẫm đạp lúa.
-
An toàn và bền vững: Bảo vệ sức khỏe nông dân, giảm ô nhiễm môi trường.
-
Ngăn chặn lây lan: Phun thuốc nhanh chóng, chính xác, ngăn bệnh lan rộng.
Airnano tự hào là đơn vị tiên phong mang công nghệ máy bay phun thuốc hiện đại đến tay bà con, giúp nâng cao hiệu quả sản xuất và bảo vệ mùa màng.

Kết Luận
Bệnh lúa von là một thách thức lớn, nhưng với sự hiểu biết và áp dụng các biện pháp phòng trừ hiệu quả, nông dân hoàn toàn có thể bảo vệ vụ mùa của mình. Từ việc chọn giống sạch, quản lý canh tác thông minh, đến sử dụng công nghệ máy bay phun thuốc tiên tiến của Airnano, mỗi bước đều là “tấm khiên” vững chắc chống lại nấm Fusarium moniliforme. Hãy cùng Airnano xây dựng một nền nông nghiệp bền vững, năng suất và an toàn!







